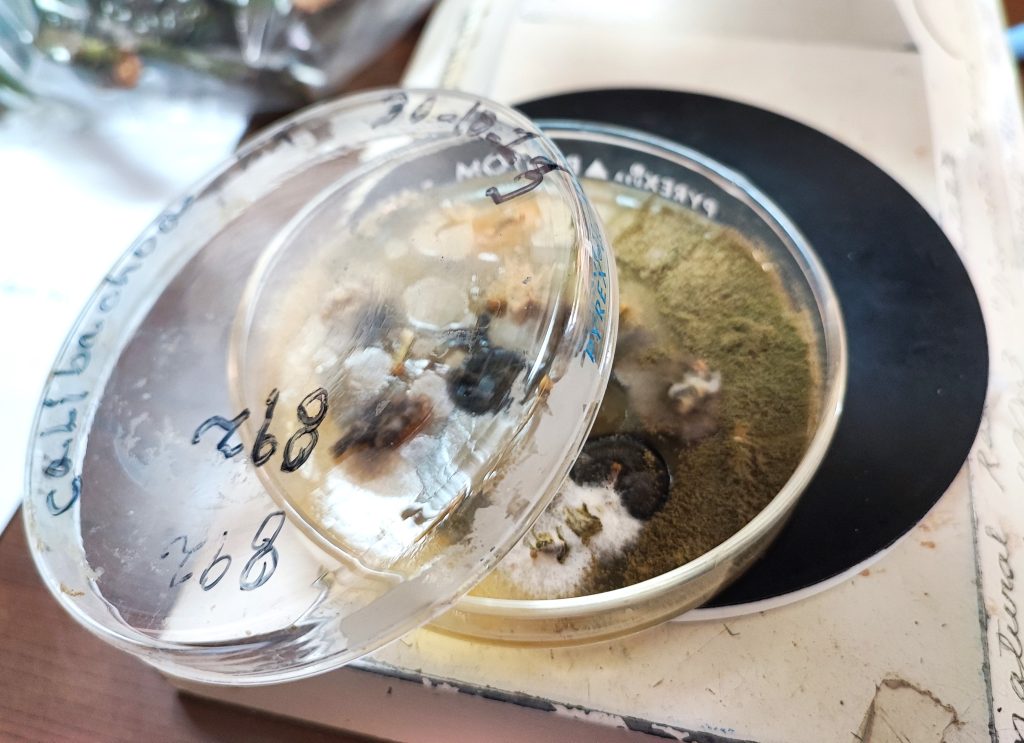

Técnicos de la Gerencia de Asistencia Alimentaria, del Ministerio de Desarrollo Local, realizaron una visita por los laboratorios de Parasitología Vegetal y Tecnología de Alimentos del Centro Nacional de Tecnología Agropecuaria y Forestal (CENTA) con la finalidad de conocer cómo identificar micotoxinas en los alimentos y la incidencia que tienen en la salud humana y animal.
La Gerencia de Asistencia Alimentaria es responsable de recibir, almacenar y operativizar la asistencia alimentaria a familias en condición de vulnerabilidad, ya sea en situaciones regulares o en condiciones de catástrofes o emergencias. Ellos canalizan los productos alimentarios e insumos no alimentarios donados o adquiridos por las instituciones del Gobierno Central. Entre los alimentos que almacenan se destaca los granos básicos: maíz, frijol y arroz, así como aceite, azúcar, espagueti, atún/sardina y mezcla de harina de maíz y soya.
Mauricio Galán, jefe de Conservación de Bodegas de la Gerencia, explica que de allí surge la necesidad de buscar los mecanismos idóneos para garantizar que estos alimentos tengan las condiciones óptimas bajo su resguardo.
“Nuestra visita obedece a que queremos innovar en nuestro servicio de almacenaje de alimentos y queremos incorporar nuevos tipos de análisis como la determinación de las micotoxinas y aprender cómo el CENTA los hace. Actualmente solo estamos realizando un análisis de calidad en un laboratorio externo, pero la idea nuestra es comenzar a realizarlos en nuestro propio laboratorio a partir del próximo año”, puntualizó.
De acuerdo a Reina Guzmán, coordinadora del laboratorio de Parasitología Vegetal, las micotoxinas son producidas por microorganismos del reino de los hongos, que pueden afectar a la salud de los animales y las personas. Esta contaminación se da en el campo, almacenamiento y etapas de elaboración del alimento.
“Cuando existen las condiciones ambientales para el desarrollo del hongo es que se da la proliferación; y cuando estas toxinas son ingeridas o inhaladas por animales o humanos, aún a concentraciones muy bajas de gramos o miligramos, producen reacciones alérgicas, inmunosupresión, cuadros nerviosos y hemorrágicos, disminución de la eficiencia productiva y reproductiva, deficiencias metabólicas y bioquímicas, enfermedades autoinmunes, alteraciones genéticas y hasta la muerte”.
Durante la visita, los técnicos tuvieron la oportunidad de ver a través de equipo microscópico especializado cómo se ven estos hongos, asimismo realizaron un recorrido por el laboratorio de Tecnología de Alimentos para conocer cómo se selecciona una muestra para realizar análisis de detección de micotoxinas por el método Elisa – AgraQuant.
Galán externó que ahora cuentan con un mejor panorama para incorporar nuevas metodologías de trabajo. La visión que tiene es que el personal se capacite y comenzar a realizarlos por su cuenta.
“La visita ha sido de mucho provecho, tenemos una mejor idea de lo que queremos hacer realidad, mi visión es que nuestro laboratorio sea un reflejo de lo que ustedes hacen aquí para poder garantizar que los alimentos que recibimos sean de calidad y estén en óptimas condiciones para quienes los reciben, la visita de este día es el primer paso”, concluyó.
Ciudad Arce, La Libertad, 17 de noviembre de 2023.
CENTA, Unidad de Comunicaciones.